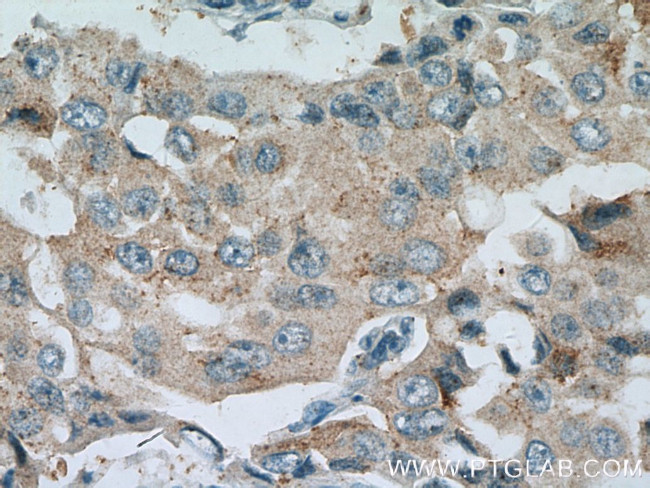
BACE2 Antibody in Immunohistochemistry (Paraffin) (IHC (P))

Search
Proteintech
BACE2 Polyclonal Antibody
{{$productOrderCtrl.translations['antibody.pdp.commerceCard.promotion.promotions']}}
{{$productOrderCtrl.translations['antibody.pdp.commerceCard.promotion.viewpromo']}}
{{$productOrderCtrl.translations['antibody.pdp.commerceCard.promotion.promocode']}}: {{promo.promoCode}} {{promo.promoTitle}} {{promo.promoDescription}}. {{$productOrderCtrl.translations['antibody.pdp.commerceCard.promotion.learnmore']}}
产品信息
16321-1-AP
种属反应
宿主/亚型
分类
类型
抗原
偶联物
形式
浓度
规格
纯化类型
保存液
内含物
保存条件
运输条件
产品详细信息
Immunogen sequence: TNRVVAPTP GPGTPAERHA DGLALALEPA LASPAGAANF LAMVDNLQGD SGRGYYLEML IGTPPQKLQI LVDTGSSNFA VAGTPHSYID TYFDTERSST YRSKGFDVTV KYTQGSWTGF VGEDLVTIPK GFNTSFLVNI ATIFESENFF LPGIKWNGIL GLAYATLAKP SSSLETFFDS LVTQANIPNV FSMQMCGAGL PVAGSGTNGG SLVLGGIEPS LYKGDIWYTP IKEEWYYQIE ILKLEIGGQS LNLDCREYNA DKAIVDSGTT LLRLPQKVFD AVVEAVARAS LIPEFSDGFW TGSQLACWTN SETPWSYFPK ISIYLRDENS SRSFRITILP QLYIQPMMGA GLNYECYRFG I (39-398 aa encoded by BC014453)
靶标信息
BACE2 or Beta Secretase 2 is responsible for the proteolytic processing of the amyloid precursor protein (APP). BACE2 cleaves APP between residues 690 and 691. This cleavage leads to the generation and extracellular release of beta-cleaved soluble APP. BACE2 is also know to cleave APP between residues 671 and 672. Accumulation of APP is a signature of Alzheimer disease and frequent complication of adult Down syndrome patients.
仅用于科研。不用于诊断过程。未经明确授权不得转售。
生物信息学
蛋白别名: 56 kDa aspartic-like protease; asp 1; ASP1; Aspartic-like protease 56 kDa; Aspartyl protease 1; be; beta secretase 2; Beta-secretase 2; beta-site amyloid beta A4 precursor protein-cleaving enzyme 2; Beta-site amyloid precursor protein cleaving enzyme 2; Beta-site APP cleaving enzyme 2; beta-site APP processing enzyme; beta-site APP-cleaving enzyme 2; Down region aspartic protease; Down syndrome region aspartic protease; DRAP; Memapsin-1; Membrane-associated aspartic protease 1; SLCO3A1/BACE2 fusion; Theta-secretase; transmembrane aspartic proteinase Asp1; unnamed protein product
基因别名: 1110059C24Rik; AEPLC; AI850424; ALP56; ARP1; ASP1; ASP21; BACE2; BAE2; CDA13; CEAP1; DRAP; UNQ418/PRO852
UniProt ID: (Human) Q9Y5Z0, (Mouse) Q9JL18, (Rat) Q6IE75
Entrez Gene ID: (Human) 25825, (Mouse) 56175, (Rat) 288227